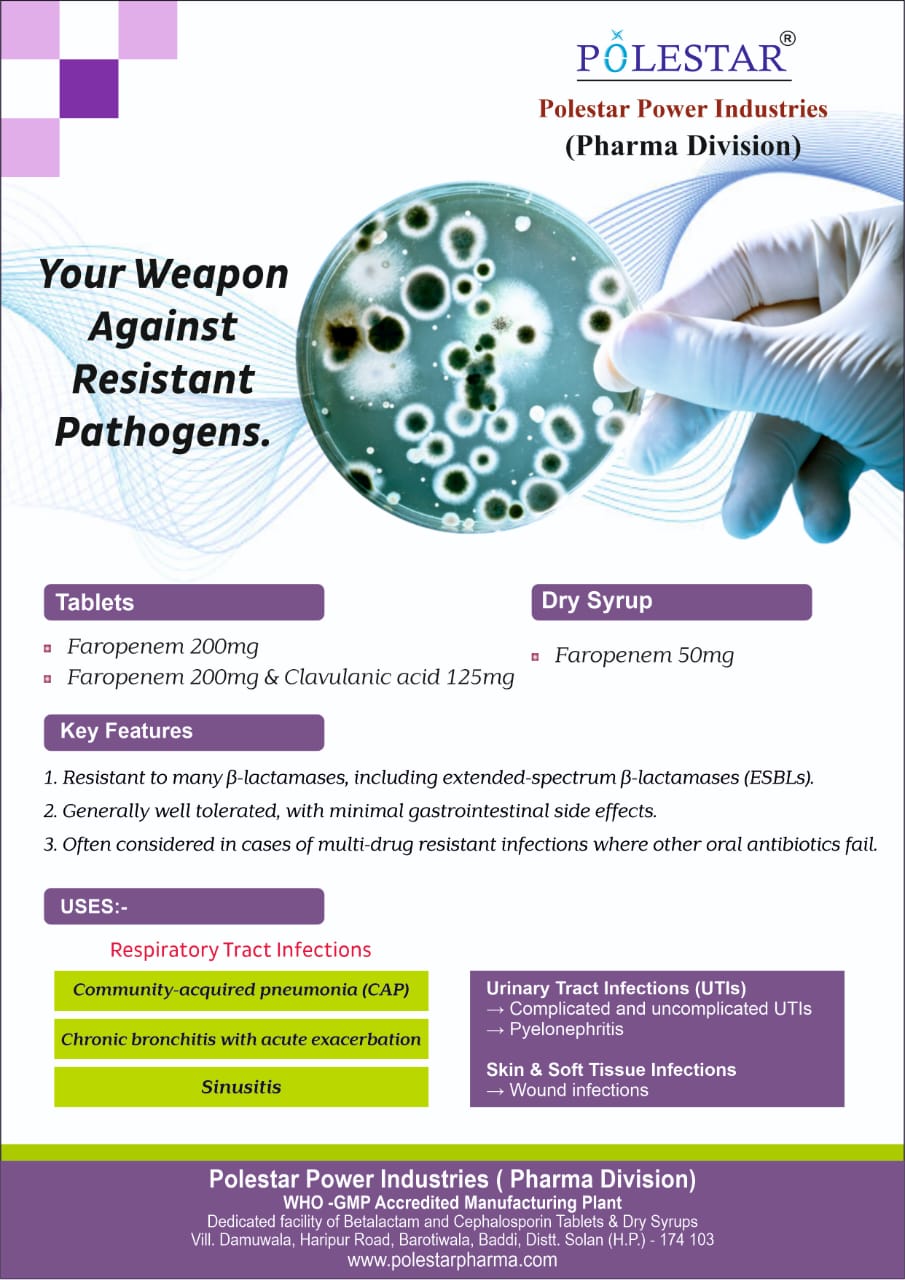

Export Tablets
A glimpse into our WHO-GMP compliant infrastructure






Export Syrup
A glimpse into our WHO-GMP compliant infrastructure



Domestic Tablets
A glimpse into our WHO-GMP compliant infrastructure















Domestic Syrup
A glimpse into our WHO-GMP compliant infrastructure






Product Showcase
A glimpse into our pharmaceutical product range and promotional materials.